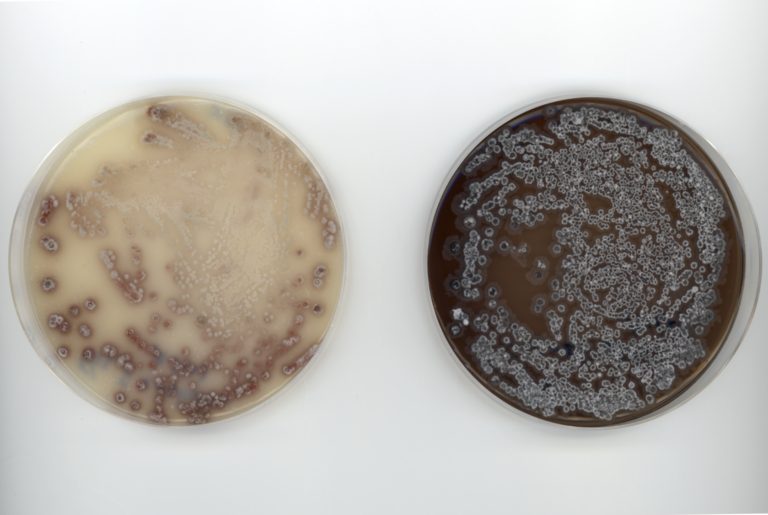
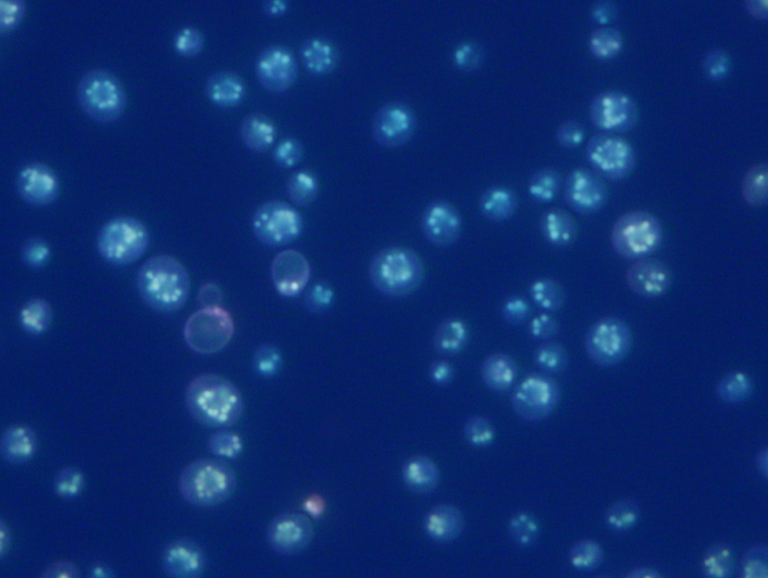

微生物活用の多様な可能性を探る
化石資源依存型社会からバイオエコノミー社会への転換が期待される中、多様な産業分野で国際競争力のあるバイオものづくりを実現するためには、新たな微生物機能の開拓・創製と、それに基づくバイオプロセスの構築が不可欠です。
微生物を活用したものづくりは、発酵産業としてなじみの深いものから、酵素や微生物菌体を触媒とした生物変換、組換えタンパク質や二次代謝産物の生産、有機廃棄物の資源化、高等生物との相互作用の活用に至るまで多岐にわたります。しかし、実際に利用されている微生物種や遺伝子は、全体のごく一部にとどまっています。
本研究グループは、微生物資源の潜在能力を最大限に引き出し、国内バイオものづくり産業の発展に貢献することを目指しています。具体的には、細菌・酵母・糸状菌など多様な微生物を対象に、新規バイオリソースのスクリーニングと機能解析、高生産微生物の作製および最適な培養条件の探索、さらにバイオプロセス構築のための技術シーズ開発に取り組んでいます。